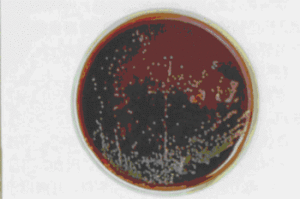
巴氏桿菌屬

分類地位
分類地位未定的1屬。為無芽孢,不運動,兼性厭氧,菌體兩端常染色濃重的革蘭氏染色陰性小桿菌。因1880年巴斯德氏首先自病雞分離到本屬中的多殺巴氏桿菌而得名。鼠疫桿菌、假結核桿菌、腸道結腸炎桿菌和土拉桿菌原歸本屬,現前三者改歸耶爾森氏菌屬,最後一種改歸弗朗西斯氏菌屬。本屬已確定的種有多殺巴氏桿菌、嗜肺巴氏桿菌、溶血巴氏桿菌、尿巴氏桿菌和鴨疫巴氏桿菌等。它們的生物學性狀見表。屬的特徵
本屬菌體大小(0.3~0.5)×(1.0~1.8)微米。卵圓形或桿狀,單個、成對或少數成短鏈。感染動物體液或組織製片中的菌體兩極濃染更為明顯。用姬姆薩氏染色液或美蘭染色,可見到薄莢膜。普通肉湯即可生長。除產氣巴氏桿菌能產生微量氣體外,本屬各成員均能利用葡萄糖等碳水化合物,產生少量酸而不產氣,有過氧化氫酶,常有氧化酶、還原硝酸鹽、不液化明膠。甲基紅(MR)反應陰性,VP反應陰性,適溫為37℃。DNA中的G+C克分子含量為36.5~40.05%。
本屬中的多殺巴氏桿菌為害畜、禽最嚴重,從發病動物體液或組織中培養分離到的菌落基本有兩型:一為過45°折光,在低倍顯微鏡下,呈現鮮明的藍綠色而帶金光,邊緣有狹窄的紅黃色帶的Fg菌落型。相當於血清型乙型。對小白鼠、家兔和豬毒力強大,每隻注射活菌10~200個即可致死,而對家禽每隻必須注射10個以上才可致死。
另一為在45°折光下,菌落呈現橘紅色,邊緣稍帶狹窄的黃綠光的FO菌落型,相當於血清型甲型。對雞、鴿毒力強大,對豬的毒力較次,家兔對兩型的致死量無甚差異。
在中國,牛、豬、驢和馬的多殺巴氏桿菌病絕大多數為Fg型菌所致,家禽流行性巴氏桿菌病都是FO型菌所致。慢性病例中偶爾發現菌落較小、折光下呈現淡藍色的菌落。自病兔分離的菌落也都是FO型。
多殺巴氏桿菌菌體抗原有12個型,莢膜抗原有5個型,前者以阿拉伯數字表示,後者以英文大寫字母表示,如1:A,2:A,1:B等。已知組成的菌型有16個。血清型與宿主的分布有一定關係。細胞壁含有明顯的內毒素活性,但未發現外毒素。本菌可引起家禽霍亂的暴發性流行,牛的出血性敗血病、原發性或繼發性肺炎等。國外免疫用的菌苗以加不同佐劑的滅活菌為主,也使用禽霍亂弱毒活菌。中國已於1959年使用弱毒活苗。
其他幾個如嗜肺巴氏桿菌可感染牛、小鼠、兔或人,引起胸膜肺炎;溶血巴氏桿菌可感染牛、羊,引起牛、羊肺炎或敗血症;巴氏桿菌可在健康人鼻中發現,偶致臭鼻病。可用磺胺藥治療,抗生素與高度免疫血清合用效果更好。
分類
(一)多殺性巴氏桿菌
多殺巴氏桿菌氏一種兩段鈍圓,中央微突的短桿菌或球桿菌,長0.6-2.5微米,寬0.25-0.6微米,不形成芽胞,不運動,無鞭毛,革蘭氏染色陰性的需氧兼性厭氧菌。本菌在添加血清或血液的培養基上生長良好。在血瓊脂上生成灰白色,濕潤而粘稠的菌落,不溶血;在普通瓊脂上形成細小透明的露珠狀菌落;在普通肉湯中,初均勻混濁,以後形成黏性沉澱和菲薄的附壁菌膜;明膠穿刺培養,沿穿刺孔呈線裝生長,上粗下細。本菌的抵抗力不強,在直射陽光和乾燥的情況下迅速死亡;60℃10min可殺死;一般消毒藥在幾分鐘或十幾分鐘內可殺死。3%石炭酸和0.1%升汞水在1min內可殺菌,10%石灰乳及常用的甲醛溶液3-4min內可使之死亡。在無菌蒸餾水和生理鹽水中迅速死亡,但在屍體內可存活1-3個月,在廄肥中亦可存活一個月。用特異性莢膜抗原(K抗原)吸附於紅細胞上作被動血凝試驗,分為A、B、D、E四型血清群;利用菌體抗原(O抗原)作凝集試驗,將本菌分為12個血清型。若將K、O兩種抗原組合在一起,迄今已有16個血清型。該病的病型,宿主特異性,致病性,免疫性等,都與血清型有關。本菌可使雞、鴨等發生禽霍亂,使豬發生豬肺疫,使各種牛、羊、兔、馬以及許多野生動物發生敗血症。
(二)溶血性巴氏桿菌
形態、培養和抵抗力與多殺性巴氏桿菌基本相似,但在血瓊脂上新分離菌菌落產生β溶血,連續繼代培養後,溶血性減弱或消失,在羔羊血瓊脂上可生成雙溶血環。在麥康凱瓊脂上能緩慢生長,菌落為紅色,不產生靛基質,一般能發酵乳糖,產酸,對家兔無致病力。根據生化反應和致病性的不同,可分為A和T兩個生物型;A型引起牛、綿羊肺炎和新生羔羊敗血症;T型引起3月齡以上的羔羊敗血症。另外還可按其可溶性莢膜抗原(K抗原)用間接紅細胞凝集試驗分為12個血清型,其中3、4、10屬於T生物型,其餘各型均屬於A生物型,所有血清型都可見於綿羊、山羊,牛僅見1型。
巴氏桿菌病
巴氏桿菌病(pasteurellosis)是由多殺性巴氏桿菌引起的一種急性、熱性傳染疾病。動物巴氏桿菌病的急性型常以敗血症和出血性炎症為主要特徵,所以過去又叫“出血性敗血症”;慢性型常表現為皮下結締組織,關節及各臟器的化膿性病灶,並多與其他疾病混合感染或繼發。
一.病原學
本病病原氏多殺性巴氏桿菌。溶血性巴氏桿菌也可成為羊、牛敗血症的病原。
(一)多殺性巴氏桿菌:多殺巴氏桿菌氏一種兩段鈍圓,中央微突的短桿菌或球桿菌,長0.6-2.5微米,寬0.25-0.6微米,不形成芽胞,不運動,無鞭毛,革蘭氏染色陰性的需氧兼性厭氧菌。本菌在添加血清或血液的培養基上生長良好。在血瓊脂上生成灰白色,濕潤而粘稠的菌落,不溶血;在普通瓊脂上形成細小透明的露珠狀菌落;在普通肉湯中,初均勻混濁,以後形成黏性沉澱和菲薄的附壁菌膜;明膠穿刺培養,沿穿刺孔呈線裝生長,上粗下細。本菌的抵抗力不強,在直射陽光和乾燥的情況下迅速死亡;60℃10min可殺死;一般消毒藥在幾分鐘或十幾分鐘內可殺死。3%石炭酸和0.1%升汞水在1min內可殺菌,10%石灰乳及常用的甲醛溶液3-4min內可使之死亡。在無菌蒸餾水和生理鹽水中迅速死亡,但在屍體內可存活1-3個月,在廄肥中亦可存活一個月。用特異性莢膜抗原(K抗原)吸附於紅細胞上作被動血凝試驗,分為A、B、D、E和F五型血清群;利用菌體抗原(O抗原)作凝集試驗,將本菌分為12個血清型。若將K、O兩種抗原組合在一起,迄今已有16個血清型。該病的病型,宿主特異性,致病性,免疫性等,都與血清型有關。本菌可使雞、鴨等發生禽霍亂,使豬發生豬肺疫,使各種牛、羊、兔、馬以及許多野生動物發生敗血症。
(二)溶血性巴氏桿菌:形態、培養和抵抗力與多殺性巴氏桿菌基本相似,但在血瓊脂上新分離菌菌落產生β溶血,連續繼代培養後,溶血性減弱或消失,在羔羊血瓊脂上可生成雙溶血環。在麥康凱瓊脂上能緩慢生長,菌落為紅色,不產生靛基質,一般能發酵乳糖,產酸,對家兔無致病力。根據生化反應和致病性的不同,可分為A和T兩個生物型;A型引起牛、綿羊肺炎和新生羔羊敗血症;T型引起3月齡以上的羔羊敗血症。另外還可按其可溶性莢膜抗原(K抗原)用間接紅細胞凝集試驗分為12個血清型,其中3、4、10屬於T生物型,其餘各型均屬於A生物型,所有血清型都可見於綿羊、山羊,牛僅見1型。
二.流行病學
病畜,病禽的排泄物,分泌物及帶菌動物均是本病重要的傳染源。本病主要通過消化道和呼吸道,也可通過吸學昆蟲和損傷的皮膚,黏膜而感染。能感染此病的動物很多,家畜中以各種牛、豬、兔、綿羊發病較多,山羊、鹿、駱駝、馬、驢、犬、貓和水貂等亦可感染髮病,但報導較少。禽類中以雞、火雞和鴨最易感,鵝、鴿次之。已有20多種野生水禽感染本病的報導。發病動物以幼齡為多,較為嚴重,病死率較高。本病的發生一般無明顯的季節性,但以冷熱交替,氣候劇變,悶熱,潮濕,多雨的時期發生較多。體溫失調,抵抗力降低,是本病主要的發病誘因之一。另外長途運輸或頻繁遷移,過度疲勞,飼料突變,營養缺乏,寄生蟲等也常常誘發此病。因某些疾病的存在造成機體抵抗力降低,易繼發本病。本病多呈地方流行或散發,同種動物能相互傳染,不同種動物之間也偶見相互傳染。
三.發病機理
當氣候,季節變化,長途運輸和寄生蟲感染,營養不良等因素導致動物機體抵抗力降低時,健康帶菌動物的呼吸道和扁桃體內所存在的巴氏桿菌,會變成強毒菌而造成內源性感染;另外可由於污染的飼料,水,空氣,器具等經消化道,呼吸道,外傷而造成外源性感染。如果機體抵抗力較弱,而侵入的時強毒菌,則會很快地通過淋巴結地阻止作用,進入血流,形成菌血症,染病動物可於24h內因敗血症死亡。如果機體抵抗力強或侵入機體的菌數不太多或毒力較弱,病程可延長1-2天或更久。如果病原菌屬於弱毒力,機體又具有較強的抵抗力,則病變會局限於局部。
四.臨床症狀
1.禽巴氏桿菌病:又稱禽霍亂(fowlcholera)自然感染的潛伏期為2-9天。(1)雞:A.最急性型:常見於流行初期,以產蛋高的雞最常見。病雞無前驅症狀,晚間一切正常,吃得很飽,次日發病死在雞舍內。B.急性型:此型最為常見,病雞主要表現為精神沉鬱,羽毛松亂,縮頸閉眼,頭縮在翅下,不願走動,離群呆立。病雞常有腹瀉,排出黃色、灰白色或綠色的稀糞。體溫升高到43~44℃,減食或不食,渴欲增加。呼吸困難,口、鼻分泌物增加。雞冠和肉髯變青紫色,有的病雞肉髯腫脹,有熱痛感。產蛋雞停止產蛋。最後發生衰竭,昏迷而死亡,病程短的約半天,長的1~3d。C.慢性型:由急性不死轉變而來,多見於流行後期。以慢性肺炎、慢性呼吸道炎和慢性胃腸炎較多見。病雞鼻孔有粘性分泌物流出,鼻竇腫大,喉頭積有分泌物而影響呼吸。經常腹瀉。病雞消瘦,精神萎頓,冠蒼白。有些病雞一側或兩側肉髯顯著腫大,隨後可能有膿性乾酪樣物質,或乾結、壞死、脫落。有的病雞有關節炎,常局限於腳或翼關節和腱鞘處,表現為關節腫大、疼痛、腳趾麻痹,因而發生跛行。病程可拖至一個月以上,但生長發育和產蛋長期不能恢復。(2)鴨:鴨巴氏桿菌病俗稱“搖頭瘟”。鴨發生急性霍亂的症狀與雞基本相似,常以病程短促的急性型為主。病鴨精神萎頓,不願下水游泳,即使下水,行動緩慢,常落於鴨群的後面或獨蹲一隅,閉目瞌睡。羽毛松亂,兩翅下垂,縮頭彎頸,食慾減少或不食,渴欲增加,嗉囊內積食不化。口和鼻有粘液流出,呼吸困難,常張口呼吸,並常常搖頭,企圖排出積在喉頭的粘液,故有“搖頭瘟”之稱,病鴨排出腥臭的白色或銅綠色稀糞,有的糞便混有血液。有的病鴨發生氣囊炎。病程稍長者可見局部關節腫脹,病鴨發生跛行或完全不能行走,還有見到掌部腫如核桃大,切開見有膿性和乾酪樣壞死。(3)其他禽類成年鵝的症狀與鴨相似,仔鵝發病和死亡較成年鵝嚴重,常以急性為主,精神萎頓,食慾廢絕,拉稀,喉頭有粘稠的分泌物。喙和蹼發紫,翻開眼結膜有出血斑點,病程1~2d即歸於死亡。鴿巴氏桿菌病來勢急,病情重,死亡快,病鴿多不食,精神沉鬱,閉目縮頸,羽毛松亂,伏臥一腳,體溫42℃以上,口渴常飲水,嗉囊脹滿,倒提時口流淡黃色黏性液體,結膜潮紅,鼻瘤失去原有灰白色,有的病鴿下痢,排出白色或綠色粘液稀糞,病程1-2天。野生水禽巴氏桿菌病主要發生於雁行目鴨科,其中海鷗表現為急性經過,突然死亡,從所棲息的山岩上掉下來,大多數表現為亞急性經過,全身症狀明顯;還有的野鴨表現失明。
2.豬巴氏桿菌病:又稱豬肺疫,潛伏期一般1-14天。根據病的發展過程,可分為最急性、急性和慢性三個病型。(1)最急性型:往往呈敗血症症狀,病豬體溫突然上升到4l℃-42℃,呼吸困難,心跳加快,不吃食,口鼻黏膜發紫。耳根、頸部、腹部等處發生出血性紅斑。咽喉腫脹,堅硬而熱;病豬呈犬坐勢,在數小時到1天內死亡。(2)急性型:往往是胸膜肺炎症狀。體溫上升至40℃-4l℃左右。呼吸困難,有短而乾的咳嗽,流鼻涕,氣喘。有粘液性或膿性結膜炎。皮膚出現出血紅紫斑。開始時便秘,後來下痢。往往在2-3天內死亡,不死的多轉為慢性。(3)慢性型:表現為持續的咳嗽,呼吸困難。病豬逐漸消瘦,有時關節發生腫脹。最後持續腹瀉,衰竭而死。
3.牛巴氏桿菌病:又稱牛出血性敗血症,潛伏期2-5天。(1)敗血型:多見於水牛,表現高熱(4l℃-42℃),精神沉鬱,結膜潮紅,鼻鏡乾燥,不食,泌乳和反芻停止,腹痛下痢,糞初為粥狀,後呈液狀並混有粘液、黏膜片和血液,具有惡臭,常於12-24h死亡。(2)水腫型:以氂牛常見,除表現全身症狀外,病牛頭、頸、咽喉及胸前皮下水腫,手指按壓初熱、硬、痛;後變涼,疼痛也減輕,舌及周圍組織高度腫脹,流涎,呼吸困難,眼紅腫,流淚,黏膜發紺,常因窒息和下痢而死,病程多為12-36h。(3)肺炎型:病牛表現急性纖維素性胸膜炎,肺炎症狀。後期有的發生腹瀉,便中帶血,有的尿血,數天至兩周死亡,有的轉為慢性型。(4)慢性型:以慢性肺炎為主,病程1個月以上。
4.羊巴氏桿菌病:(1)最急性型:多見於哺乳羔羊,突然發病,出現寒戰、虛弱、呼吸困難等,常在數小時內死亡。(2)急性型:病羊精神沉鬱,體溫升高到41~42℃,咳嗽,鼻孔流血並混有黏液。病初便秘,後期腹瀉,有的糞便呈血水樣,最後因腹瀉脫水而死亡。(3)慢性型:病羊消瘦,食慾減退,咳嗽,呼吸困難,死前極度消瘦。
5.兔巴氏桿菌病:巴氏桿菌是引起9周齡至6月齡的兔死亡的最主要原因。潛伏期長短不一,一般從幾小時到5天或更長。(1)出血性敗血症型:最急性的常無明顯症狀而突然死亡。生產中以鼻炎和肺炎混合發生的敗血症最為多見,可表現為精神萎靡不振,食慾減退但沒有廢絕,體溫升高,鼻腔流出漿液性、黏液性或膿性鼻液,有時腹瀉。臨死前體溫下降,四肢抽搐,病程數小時至3天。(2)傳染性鼻炎型:鼻腔流出漿液性、黏液性或膿性分泌物,呼吸困難,打噴嚏、咳嗽,鼻液在鼻孔處結痂,堵塞鼻孔,使呼吸更加困難,並出現呼嚕聲。由於患兔經常以爪撓抓鼻部,可將病菌帶入眼內、皮下等,誘發其他病症。病程一般數日至數月不等,治療不及時多衰竭死亡。(3)地方性肺炎型:常由傳染性鼻炎繼發而來。由於獺兔的運動量很小,自然發病時很少看出肺炎症狀,直到後期嚴重時才表現為呼吸困難。患兔食欲不振、體溫升高、精神沉鬱,有時會出現腹瀉或關節腫脹症狀,最後多因肺嚴重出血、壞死或敗血而死。(4)中耳炎型:又稱斜頸病,是病菌擴散到內耳和腦部的結果。其頸部歪斜的程度不一樣,發病的年齡也不一致。有的剛斷奶的小兔就出現頭頸歪斜,但多數為成年兔。嚴重的患兔,向著頭傾斜的一方翻滾,一直到被物體阻擋為止。由於兩眼不能正視,患兔飲食極度困難,因而逐漸消瘦。病程長短不一,最終因衰竭而死。(5)結膜炎型:臨床表現為流淚,結膜充血、紅腫,眼內有分泌物,常將眼瞼粘住。(6)膿腫、子宮炎及睪丸炎型:膿腫可以發生在身體各處。皮下膿腫開始時,皮膚紅腫、硬結,後來變為波動的膿腫。子宮發炎時,母體陰道有膿性分泌物。公兔睪丸炎可表現一側或兩側睪丸腫大,有時觸摸感到發熱。
6.馬屬動物巴氏桿菌病:馬屬動物巴氏桿菌病主要發生於幼駒,驢罕見。(1)麻痹型:病駒表現高熱(40℃以上),精神沉鬱,結膜潮紅,脈搏增數,後期反應遲鈍或完全小時,唇下垂不能回縮,伏臥時,前肢外展,後肢伸向後外方,膝部著地,口唇支地,病程幾小時至2天。(2)水腫型:病駒體溫稍高(40℃左右),脈搏增數,四肢和脊柱兩側反應敏感,在頰、唇、鼻樑、頸部和肩前部等處出現炎性腫脹。(3)興奮型:可見於驢,表現體溫微高,胸部炎性水腫,經常啃咬胸部,死前怪叫、滾轉、衝撞等神經症狀,病程2-3天。
7.鹿巴氏桿菌病:潛伏期1-5天,分為兩型。(1)急性敗血型:病鹿表現嚴重的全身症狀,常於1-2天死亡。(2)肺炎型(胸型):病鹿除全身症狀外,表現咳嗽,呼吸迫促,步態不穩,嚴重病例呼吸極度困難,頭向前伸,鼻翼扇動,口吐白沫,糞稀,全身肌肉震顫,最後臥地不起,經1-5天死亡。
8.貉巴氏桿菌病:(1)急性型:多數病貉暴死,多見於當年出生的仔貉,病初精神沉鬱,體溫達40℃以上時,食慾減少、不久廢絕,鼻部乾燥、呼吸困難,喜歡涼水,運步不靈活,常呈痙攣性抽搐而死亡,病程一般為1-3天。(2)慢性型:症狀與急性型基本相同,只是病程長,最後因麻痹,衰竭而死。
9.水貂巴氏桿菌病:(1)最急性型:常未見症狀而暴死。(2)急性型:多見,表現為體溫升高達41℃,鼻部乾燥,病初食慾減少,後期廢絕,很少活動或不動,呼吸困難,有時出現四肢麻痹,多在昏迷或痙攣中死亡,病程1-5天。10.銀黑狐巴氏桿菌病:多突然發病,表現為食慾減少,甚至廢絕,呼吸急促,精神沉鬱,被毛蓬亂,常臥於籠內一側,眼結膜潮紅,有粘性眼屎,體溫達40-42℃,鼻流漿性鼻液。病初下痢,後期排血糞。病程幾小時至2天。
五.病理變化
由於機體抵抗力、細菌毒力和侵入菌數不同,以及各種畜禽對本菌的易感性不同,因此,病理變化亦有差異。
1.禽:最急性型死亡的病雞無特殊病變,有時只能看見心外膜有少許出血點。急性病例病變較為特徵,病雞的腹膜、皮下組織及腹部脂肪常見小點出血。心包變厚,心包內積有多量不透明淡黃色液體,有的含纖維素絮狀液體,心外膜、心冠脂肪出血尤為明顯。肺有充血或出血點。肝臟的病變具有特徵性,肝稍腫,質變脆,呈棕色或黃棕色。肝表面散布有許多灰白色、針頭大的壞死點。脾臟一般不見明顯變化,或稍微腫大,質地較柔軟。肌胃出血顯著,腸道尤其是十二指腸呈卡他性和出血性腸炎,腸內容物含有血液。慢性型因侵害的器官不同而有差異。當呼吸道症狀為主時,見到鼻腔和鼻竇內有多量粘性分泌物,某些病例見肺硬變。局限於關節炎和腱鞘炎的病例,主要見關節腫大變形,有炎性滲出物和乾酪樣壞死。公雞的肉髯腫大,內有乾酪樣的滲出物,母雞的卵巢明顯出血,有時卵泡變形,似半煮熟樣。鴨的病理變化與雞基本相似,死於禽霍亂的鴨在心包內充滿透明橙黃色滲出物,心包膜、心冠脂肪有出血斑。肺呈多發性肺炎,間有氣腫和出血。鼻腔黏膜充血或出血。肝略腫大,表現有針尖狀出血點和灰白色壞死點。腸道以小腸前段和大腸黏膜充血和出血最嚴重;小腸後段和盲腸較輕。雛鴨為多發性關節炎,主要可見關節面粗糙,附著黃色的乾酪樣物質或紅色的肉芽組織。關節囊增厚,內含有紅色漿液或灰黃色、混濁的粘稠液體。肝臟發生脂肪變性和局部壞死。
2.豬:最急性:咽喉黏膜有急性炎症,周圍組織漿液浸潤。淋巴結出血腫脹。肺急性水腫,腎及膀胱可能有出血點。除皮膚有出血斑外,黏膜有時也有小點出血。脾不腫大。急性型:主要為胸膜肺炎,肺有各期肺炎病變,有出血斑點、水腫、氣腫和紅色肝變區,或有纖維樣粘附物,常與胸膜粘連。支氣管淋巴結腫大,胃腸道有卡他性炎或出血性炎。慢性型的肺見多處壞死灶。胸膜及心包有纖維素絮狀物附著。確診時,可採取病豬的肝、脾和淋巴結作塗片染色鏡檢,發現兩極染色小桿菌,結合病狀、剖檢和病史即可作出確診。
3.牛:牛敗血型一般為敗血症變化;水腫型病例見於頭、頸和咽喉部水腫。急性淋巴結炎和肝、腎、心等實質器官發生變性,脾腫大罕見。肺炎型主要表現為纖維素性肺炎和胸膜炎,肺臟切面大理石樣變。
4.羊:皮下有液體浸潤和小出血點。黏膜、漿膜及內臟出血,胸腔積液,肺瘀血,有小出血點和肝變。其他臟器水腫、充血、間有小出血點,但脾不腫大,胃腸有出血性炎症;病程較長者屍體消瘦,皮下膠樣浸潤,常見纖維素性胸膜炎、肺炎和心包炎,肝有壞死灶。
5.兔:死於鼻炎型病兔的鼻腔積有多量粘性或膿性分泌物,鼻竇和副鼻竇內有分泌物,竇腔內層黏膜紅腫;肺炎型常表現為急性纖維素性肺炎和胸膜炎變化;敗血症型除一般敗血病變化外,常見鼻炎和肺炎的變化,肝臟變性,並有許多壞死小點;中耳炎型的鼓膜和鼓室內壁變紅,有時鼓室破裂,膿性滲出物流入外耳道,嚴重時出現化膿性腦膜炎的病變。
6.馬:馬巴氏桿菌病主要在胸膜、心包膜和腸管漿膜以及心冠脂肪有大量出血點,肺尖葉常見出血點,肝、脾常無明顯變化;而病死驢的肝臟有大量壞死點,脾邊緣有點狀出血,胃幽門部有出血斑,膀胱黏膜有彌散性點狀出血。
7.鹿:病死鹿的皮下組織有大量漿液浸潤並有散在出血點,真胃和腸道出血性炎症,尤其是十二指腸和盲腸出血明顯,有肺炎變化,淋巴結充血、水腫,出血。
8.貉:病死貉的急性病例,營養良好,屍僵不完全,結膜貧血,口腔黏膜有瘀血斑,心冠有出血點,心內膜乳頭肌基部有小瘀血斑,肺氣腫;表面有出血點,腸淋巴結腫大,切面多汁,胃內黏膜易脫落並有出血點,小腸黏膜出血,大腸呈卡他性腸炎,脾臟出血,但不腫大,肝臟腫大,表面有灰白色壞死灶,膀胱、黏膜有出血點;慢性病例營養不良,機體消瘦,貧血,各實質器官漿膜、黏膜出血,胃壁變薄,局限性出血,繼發肺炎時,肺尖葉,心葉有炎症變化。
9.水貂:病死水貂以實質器官和黏膜、漿膜出血為主要特徵,體表淋巴結腫大,腸系膜淋巴結有小出血點。
10.銀黑狐:病死銀黑狐屍體營養良好。皮下組織、黏膜、漿膜上均有針尖大至粟粒大的出血點。鼻腔、氣管內有粘液,且有大量出血點,肺臟呈暗紅色,表面有大小不等的彌散性出血,切面多汁,肺門淋巴結腫大。心外膜及心包膜有針尖大出血點。肝臟腫大,表面有大量出血斑和灰白色壞死灶。脾臟也腫大,呈櫻桃紅色。腎臟散在出血點。胃腸黏膜廣泛出血。
六.診斷
1.微生物學檢查:(1)病料採集:取病畜禽的組織,肝,肺,脾等體液、分泌物及局部病灶的滲出液。(2)鏡檢:對原始病料塗片進行革蘭氏染色,鏡檢,應為革蘭氏陰性。用印度墨汁等染料染色,可見清晰的莢膜。(3)培養:同時接種鮮血瓊脂和麥康凱瓊脂培養基,37℃培養24h,觀察細菌的生長情況,菌落特徵、溶血性,並染色鏡檢。(4)生化試驗:多殺性巴氏桿菌在48h內可分解葡萄糖、果糖、單奶糖、蔗糖和甘露糖,產酸不產氣。一般不發酵乳糖、鼠李糖、菊糖、水楊苷和肌醇。可產生硫化氫,能形成靛基質,MR和V-P試驗均為陰性。接觸酶和氧化酶試驗均為陽性。溶血性巴氏桿菌不產生靛基質,能發酵乳糖產酸。能發酵葡萄糖、糖元、肌醇、麥芽糖、澱粉;不發酵側金盞花醇、菊糖和赤蘚醇。
2.動物試驗:常用的試驗動物有小鼠和家兔。實驗動物死亡後立即剖檢,並取心血和實質臟器分離和塗片染色鏡檢,見大量兩極濃染的細菌即可確診。
3.血清型或生物型鑑定:可用被動血凝試驗、凝集試驗鑑定多殺性巴氏桿菌莢膜血清群和血清型。用間接血凝試驗測溶血性巴氏桿菌的血清型,根據生化反應鑑定該菌的生物型。
七.防制
1.禽:
加強雞群的飼養管理,平時嚴格執行雞場獸醫衛生防疫措施,以棟舍為單位採取全進全出的飼養制度,預防本病的發生是完全有可能的。一般從未發生本病的雞場不進行疫苗接種。
雞群發病應立即採取治療措施,有條件的地方應通過藥敏試驗選擇有效藥物全群給藥。磺胺類藥物、氯黴素、紅黴素、慶大黴素、環丙沙星、恩諾沙星、喹乙醇均有較好的療效。在治療過程中,劑量要足,療程合理,當雞隻死亡明顯減少後,再繼續投藥2~3d以鞏固療效防止復發。
對常發地區或雞場,藥物治療效果日漸降低,本病很難得到有效地控制,可考慮套用疫苗進行預防,由於疫苗免疫期短,防治效果不十分理想。在有條件的地方可在本場分離細菌,經鑑定合格後,製作自家滅活苗,定期對雞群進行注射,經實踐證明通過1~2年的免疫,本病可得到有效控制。現國內有較好的禽霍亂蜂膠滅活疫苗,安全可靠,可在0℃下保存二年,易於注射,不影響產蛋,無毒副作用,可有效防制該病。
2.豬:
加強飼養管理,消除可能降低抗病力的因素。新引進的豬要隔離觀察一個月後再合群。圈欄要定期用10%石灰乳消毒。每年春秋定期用豬肺疫氫氧化鋁甲醛菌苗或豬肺疫口服弱毒菌苗進行兩次免疫接種。前者股下側皮下注射5毫升,注苗後14天產生免疫力;後者可按瓶簽要求套用,注苗後7天產生免疫力。如在流行時,特別是發生散發性的豬肺疫,應立即進行隔離,消毒,病豬進行治療或淘汰,"在消除發病誘因的情況下,經三周再無新病例出現,始能注射菌苗。治療用青黴素、鏈黴素和土黴素等均有一定療效。九一四(靜注,每公斤體重0.015克)也有一定療效。
3.牛:
(1)病牛隔離飼養。
(2)藥物治療①2%氧氟沙星針劑每公斤體重3~5毫克肌肉注射,複方慶大黴素針劑肌肉注射每日2次,3天為1個療程。②乳酸環丙沙星粉劑全群飲水。③10%石灰水消毒圈舍,每日2~3次。④注射牛出敗疫苗。
4.羊:
(1)搞好圈舍環境衛生,定期用2%~4%火鹼進行消毒。
(2)注意環境的改變,如氣溫突變、運輸、飼料改變等要採用藥物預防。
(3)治療及預防可用抗生素和磺胺類藥物。
5.兔:
兔場應自繁自養。引進種兔要嚴格檢查,隔離觀察一個月,進行細菌學檢查後,健康者方可進入兔場。要加強飼養管理,兔場嚴禁畜禽出入,以預防傳染源。發病後隔離、封鎖的期限一般為20天。重病兔捕殺。流鼻涕、咳嗽的病兔應及時隔離治療,慢性病兔要淘汰。兔舍用10%--20%石灰乳或2%--3%燒鹼液定期進行消毒。預防時可用兔巴氏桿菌氫氧化鋁菌苗或禽巴氏桿菌菌苗兔疫注射,或用兔瘟、兔巴氏桿菌二聯苗免疫注射。每年兩次。治療可用鏈黴素肌肉注射每公斤體重2--4萬單位,1日2次,連用3--5日;若配合青黴素(計量相同)聯合套用,效果更好。磺胺嘧啶片每公斤體重0.05--0.2g,配合等量的小蘇打片服用,每日兩次。氯黴素針劑每公斤體重60--100mg,片劑按每隻兔0.1--0.15g,每日兩次,有良好的效果。四環素、卡拉黴素、磺胺增效劑都有效。
急性病例,皮下注射抗出敗多價血清,每公斤體重約60ml,1日2次有顯著效果。對有明顯呼吸症狀的病兔,可用氯黴素等抗菌藥物滴鼻,每次3--4滴,1日2次有顯著療效。
6.其他:
發現本病時,應立即採取隔離、緊急免疫、藥物防治、消毒等措施;將已發病或體溫身高的動物全部隔離,健康的動物立即接種疫苗,或用藥物預防,對污染的環境進行徹底消毒。
內臟及病變顯著的肉屍作工業用或銷毀;無病變或病變輕微且被割除的肉屍,高溫處理後出場;血液作工業用,皮毛、羽毛消毒後出場。
從國外輸入活體動物經檢疫發現有巴氏桿菌病,退回或撲殺銷毀,同群其他動物放行至指定場所隔離觀察。輸入動物產品檢疫有巴氏桿菌病病原時作除害、退回或銷毀處理。